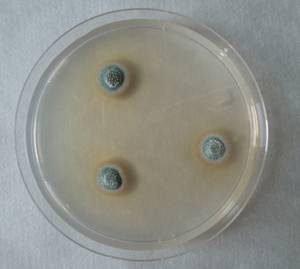
MSU_FS-01877, Район Лак (Lắk district), Đắk Lắk province (Vietnam)
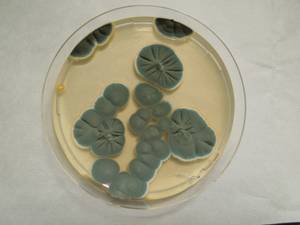
MSU_FS-01395 01, Район Лак (Lắk district), Đắk Lắk province (Vietnam)

Total items: 5
Total pages: 1
Organisms

- Specimen ID
- 0000002676313
- Species
- Penicillium glandicola
- Strain
- F-772
- Place of isolation
- Мытищинский район, Moscow Oblast (Russia)
- Placename
- Лобня

- Specimen ID
- 0000000905290
- Species
- Penicillium glandicola
- Strain
- MSU_FS-02243
- Place of isolation
- Район Лак (Lắk district), Đắk Lắk province (Vietnam)
- Placename
- Бонг Кранг (Bông Krang)
- Specimen ID
- 0000000904854
- Species
- Penicillium glandicola
- Strain
- MSU_FS-01877
- Place of isolation
- Район Лак (Lắk district), Đắk Lắk province (Vietnam)
- Placename
- Бонг Кранг (Bông Krang)
- Specimen ID
- 0000000904250
- Species
- Penicillium glandicola
- Strain
- MSU_FS-01395
- Place of isolation
- Район Лак (Lắk district), Đắk Lắk province (Vietnam)
- Placename
- Бонг Кранг (Bông Krang)

- Specimen ID
- 0000000612770
- Species
- Penicillium glandicola
- Strain
- MSU_FS-02889
- Place of isolation
- Район Манг Занг (Mang Yang districts), Gia Lai province (Vietnam)
- Placename
- Адзун (A Yun commune)